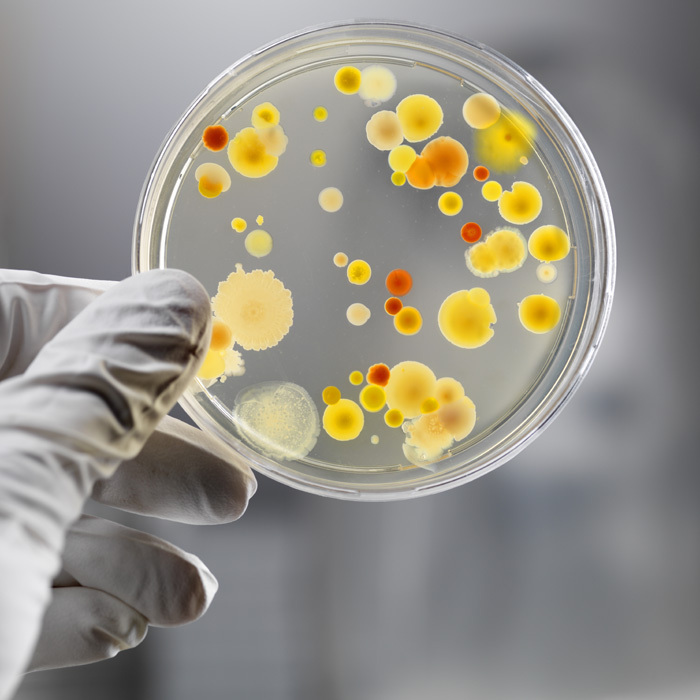

Американские микробиологи из Университета Аризоны назвали семь самых грязных предметом в доме.
1 место
Разделочная доска
Разделочные доски необходимо тщательно мыть в горячей воде, а затем тщательно вытирать. Рекомендуется иметь минимум шесть досок для сырых птиц, рцбц, мяса, для вареных продуктов, для овощей и фруктов, для хлеба.
2 место
Трубка домашнего телефона/мобильный телефон
Любой телефонный аппарат необходимо тщательно протирать один раз в два-три дня, мобильный телефон – ежедневно. Для протирки используйте сначала влажную тряпку, а затем сухую.
3 место
Губка для мытья посуды
Ученые рекомендуют менять губку для мытья посуды каждую неделю, так как за этот период она накапливает то необходимое число микробов, которое делает ее не помощником на кухне, а врагом.
4 место
Душевая зановеска
Действительно, кто-то привык к тому, что занавеска для душа покупается один раз и навсегда, кто-то меняет ее вместе с ремонтом, кто-то, возможно, немного чаще. Но при этом ученые советуют менять душевую зановеску не реже одного раза в месяц.
5 место
Мусорные корзины на кухне и в ванной
Мусорные корзины и ведра нужно мыть, и это – всем известный факт. Просто протереть влажной тряпочкой недостаточно. Их нужно тщательно чистить специальными дезинфицирующими средствами два раза в месяц.
6 место
Посудомоечная машина
Казалось бы, зачем ее мыть, если внутри нее при мытье посуды и так очень высокие температуры, плюс моюющее средство… Но в них есть резиновые уплотнители, на которых собирается наибольшее количество микробов. Поэтому посудомоечную машину рекомендуется чистить специальными дезинфицирующими средствами не менее одного раза в неделю.
7 место
Стиральная машина
Здесь работает тот же принцип, что и с посудомоечной машиной. Пунктом активного сбора микробов являются всете же резиновые уплотнители, которые необходимо дезинфицировать специальными средствами не менее одного раза в месяц.
Автор: Алёна Быкова
 Дзебак Владимир
РОЗДУМИ ПРО НАДВАЖЛИВЕ або ЧОМУ НАШІ ОЛІГАРХИ СТАЛИ МОГИЛЬЩИКАМИ НИНІШНЬОЇ УКРАЇНИ
Дзебак Владимир
РОЗДУМИ ПРО НАДВАЖЛИВЕ або ЧОМУ НАШІ ОЛІГАРХИ СТАЛИ МОГИЛЬЩИКАМИ НИНІШНЬОЇ УКРАЇНИ